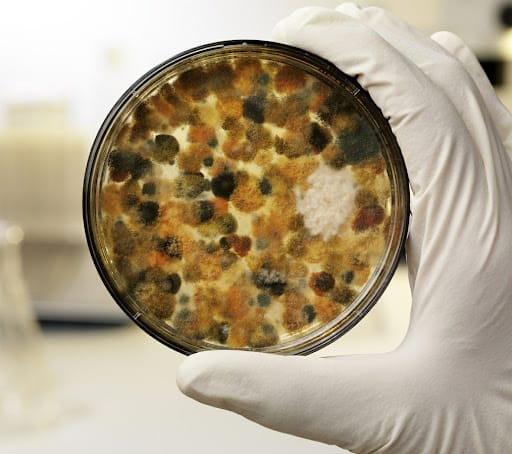

Giới Thiệu về Kit ELISA XN Ung Thư
Trong cuộc chiến chống lại ung thư, việc phát hiện sớm luôn là chìa khóa giúp tăng cơ hội chữa trị thành công. Kit ELISA XN Ung Thư, một sản phẩm đến từ hãng Bios – Mỹ, là công cụ không thể thiếu trong phòng lab hiện đại. Được thiết kế để sử dụng với các thiết bị máy miễn dịch ELISA của hãng Awareness – Mỹ, bộ kit này bao gồm 96 test, cho phép thực hiện nhiều loại xét nghiệm khác nhau, từ AFP, PSA, CEA, đến CA 125 và Beta-HCG, mỗi loại liên kết với một loại ung thư cụ thể.
Cách Thức Hoạt Động của Kit ELISA
Phương pháp ELISA (Enzyme-Linked Immunosorbent Assay) là một kỹ thuật xét nghiệm miễn dịch enzymatic cho phép phát hiện và định lượng các chất cụ thể trong một mẫu, như protein, hormone, peptit, hoặc kháng thể. Sự khác biệt của Kit ELISA từ Bios USA nằm ở việc tối ưu hóa cho độ nhạy và độ chính xác cao, đồng thời đảm bảo tính tương thích tuyệt vời với máy miễn dịch ELISA Awareness USA.
Các Loại Xét Nghiệm Có Thể Thực Hiện
Bộ kit hỗ trợ một loạt các xét nghiệm ung thư thông qua việc phát hiện các marker sinh học trong máu. Cụ thể, xét nghiệm AFP liên quan đến ung thư gan; PSA và FPSA cho ung thư tuyến tiền liệt; CEA cho nhiều loại ung thư như ruột kết, dạ dày; và các xét nghiệm khác như NSE, Ferritin, CA 199, CA 153, CA 125, Beta-HCG đều đóng vai trò quan trọng trong việc chẩn đoán sớm và theo dõi tiến trình điều trị ung thư.
Ưu Điểm của Kit ELISA XN Ung Thư
Kit ELISA XN Ung Thư đem lại nhiều ưu điểm vượt trội, bao gồm độ chính xác cao, khả năng phát hiện sớm, và linh hoạt trong việc áp dụng cho nhiều loại ung thư. Sự kết hợp giữa kit ELISA và máy miễn dịch ELISA Awareness đảm bảo cho việc xét nghiệm diễn ra một cách nhanh chóng, chính xác, giúp bác sĩ có thể đưa ra quyết định điều trị kịp thời và hiệu quả.
Hướng Dẫn Sử Dụng Kit ELISA
Kit ELISA XN Ung Thư cung cấp một hướng dẫn sử dụng chi tiết, giúp người dùng có thể tiến hành các xét nghiệm một cách chính xác nhất. Từ việc chuẩn bị mẫu xét nghiệm đến quy trình thực hiện, mỗi bước đều được mô tả tỉ mỉ, đảm bảo rằng người dùng có thể tận dụng tối đa hiệu quả của kit.
- Chuẩn bị Mẫu Xét Nghiệm: Mô tả cách thức lấy mẫu, bảo quản và chuẩn bị mẫu trước khi tiến hành xét nghiệm.
- Quy Trình Thực Hiện Xét Nghiệm: Bước-by-bước hướng dẫn về cách tiến hành xét nghiệm, từ việc thêm mẫu đến phát hiện kết quả.
Thiết Bị Hỗ Trợ – Máy Miễn Dịch ELISA Awareness USA
Một phần không thể tách rời khi sử dụng Kit ELISA XN Ung Thư chính là máy miễn dịch ELISA của hãng Awareness USA. Máy này được thiết kế để tối ưu hóa quá trình phát hiện và định lượng, giúp tăng độ chính xác của các xét nghiệm.
- Tính năng Nổi Bật: Giới thiệu chi tiết về các tính năng, công nghệ nổi bật của máy miễn dịch ELISA Awareness.
- Sự Tương Thích với Kit ELISA: Mô tả mức độ tương thích và cách thức hai sản phẩm này hoạt động cùng nhau để mang lại kết quả xét nghiệm chính xác nhất.
Các Ứng Dụng Của Kit ELISA Trong Chẩn Đoán Ung Thư
Khả năng áp dụng Kit ELISA trong việc chẩn đoán và theo dõi ung thư là một bước tiến quan trọng trong lĩnh vực y học. Phần này sẽ khám phá sâu hơn về các ứng dụng cụ thể, cũng như lợi ích mà Kit ELISA mang lại trong việc phát hiện sớm và giám sát tiến trình điều trị ung thư.
- Phát Hiện Sớm: Tầm quan trọng của việc phát hiện sớm các dấu hiệu của ung thư và vai trò của Kit ELISA trong quá trình này.
- Giám Sát Tiến Trình Điều Trị: Cách thức Kit ELISA giúp theo dõi hiệu quả của việc điều trị, qua đó giúp điều chỉnh phương pháp điều trị một cách kịp thời.
So Sánh Với Các Phương Pháp Xét Nghiệm Khác
Mặc dù Kit ELISA mang lại nhiều lợi ích, nhưng cũng cần phải xem xét và so sánh với các phương pháp xét nghiệm khác để có cái nhìn toàn diện. Phần này sẽ đưa ra một cái nhìn sâu sắc về ưu và nhược điểm của Kit ELISA so với các phương pháp khác, giúp người đọc có cái nhìn khách quan nhất.
- Ưu Điểm: Nhấn mạnh vào độ chính xác, độ nhạy cao, và khả năng áp dụng rộng rãi của Kit ELISA.
- Nhược Điểm: Đề cập đến bất kỳ hạn chế nào mà phương pháp này có thể có so với các lựa chọn khác.
SẢN PHẨM: https://mptmedical.com.vn/kit-elisa-xet-nghiem-ung-thu/